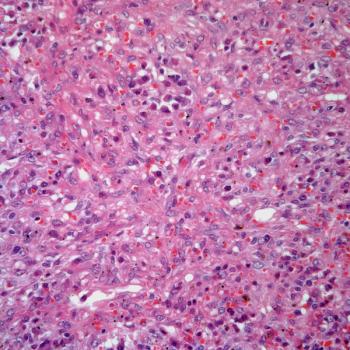
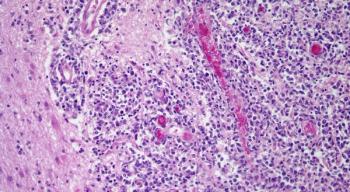
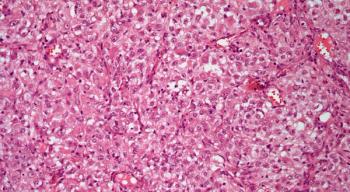

A 38-year-old man presents with abdominal pain and general malaise. What is your diagnosis?

Your AI-Trained Oncology Knowledge Connection!

A 38-year-old man presents with abdominal pain and general malaise. What is your diagnosis?

A 43-year-old woman with history of Sjogren syndrome presents with dyspnea and chest pain. What is your diagnosis?

A 42-year-old woman presents with a nodule in the right breast. What is your diagnosis?

A 35-year-old woman presents with a subcutaneous lesion in the right forearm. What is your diagnosis?

A 38-year old woman presents with an ovarian tumor and a biopsy is obtained. What is your diagnosis?

A 34-year-old man presents with pain in the right side of the neck, and a lymph node biopsy is performed. What is your diagnosis?

A 38-year-old woman presents with a breast mass and a biospy is obtained. What is your diagnosis?

A 52-year-old woman presents with symptoms of dysphagia and dyspnea. At clinical examination, a palpable soft nodule is present in the right side of the neck. What is your diagnosis?

A 56-year-old man presents with a subcutaneous soft tissue mass in the right leg. The patient does not have any other pertinent clinical history. What is your diagnosis?

A thyroid nodule is found in a 43-year-old man and a biopsy is obtained. What is your diagnosis?

A 23-year-old woman presents with cervical lymphadenopathy and a biopsy is obtained. What is your diagnosis?

A 43-year-old woman presents with symptoms of dyspnea, wheezing, and shortness of breath. Diagnostic imaging reveals a tumor mass partially obstructing the bronchus of the left lung. What is your diagnosis?

A 34-year-old man presents with axillary lymphadenopathy, and a biopsy is obtained. What is your diagnosis?

A breast nodule is found in a 42-year-old woman, and a biopsy is performed. What is your diagnosis?

A 58-year-old man presents with a mass in his larynx, and a biopsy is obtained. What is your diagnosis?

A breast mass is found in a 46-year-old woman, and a biopsy is obtained. What is your diagnosis?

An 11-year-old child presents with a lesion in the mandible, and a biopsy is obtained. What is your diagnosis?

A 53-year-old man presents with a nasal mass, and a biopsy is obtained. What is your diagnosis?

A 42-year-old woman presents with a lesion in the parotid gland, and a biopsy is obtained. What is your diagnosis?

A 37-year-old man presents with a neck mass, and a biopsy is obtained. What is your diagnosis?

A 52-year-old man presents with a mass in his right adrenal gland, and a biopsy is performed. What is your diagnosis?
A 58-year-old man presents with severe headaches, and a biopsy is obtained. What is your diagnosis?

A 46-year-old man presents with a thyroid mass, and a biopsy is obtained. What is your diagnosis?

A 47-year-old woman presents with a nodule of the right adrenal gland, and a biopsy is obtained. What is your diagnosis?

A 35-year-old man presents with severe headaches, and a biopsy is obtained. What is your diagnosis?

A 63-year-old man presents with pleural thickening, and a biopsy is performed. What is your diagnosis?

A 47-year-old woman develops a mass in her left breast, and a biopsy is performed. What is your diagnosis?

A 43-year-old woman develops a mass in her right breast, and a biopsy is obtained. What is your diagnosis?
A 53-year old woman presents with multiple peritoneal nodules, and a biopsy is obtained. What is your diagnosis?

A 47-year-old woman develops a nodule in her right breast, and a biopsy is performed. What is your diagnosis?